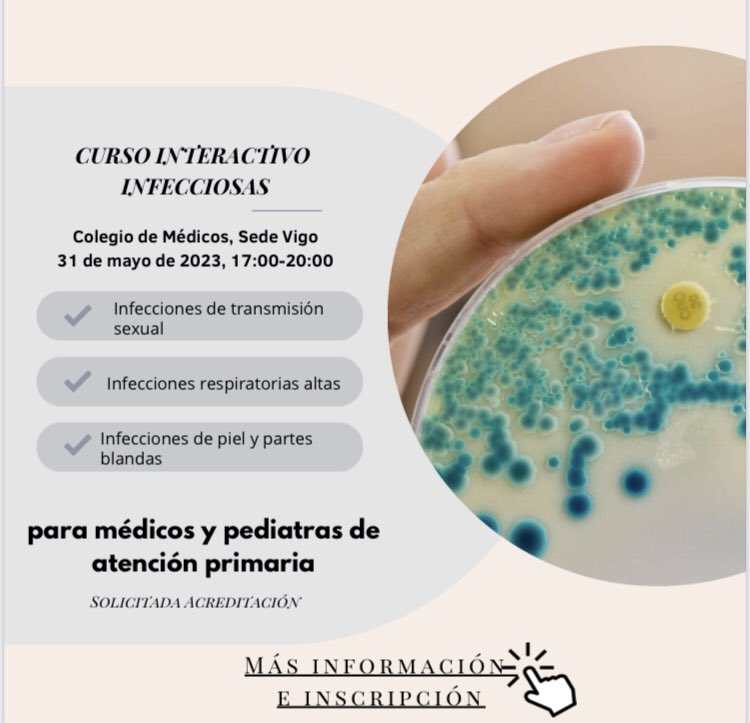
PROA_Vigo tweet media

A. Pérez Landeiro retweetledi
A. Pérez Landeiro
207 posts

A. Pérez Landeiro retweetledi

Ya abierto el plazo para apuntarte en el curso interactivo de infecciosas 🦠🧫para médicos y pediatras de #atencionprimaria en Colegio Médico de Pontevedra
Información e inscripción en enlace
cmpont.es/fundacion/form…
@PRANgob @GEIRAS_SEIMC @SEIMC_
Español
A. Pérez Landeiro retweetledi

Actualización (marzo 2022) principales recomendaciones de la guía OMS sobre tratamiento farmacológico de #COVID19
🆕recomendación sobre molnupiravir
✳️casirivimab-imdevimab (confirmar variante)
📚A living @WHO guideline on drugs for covid-19 @bmj_latest bmj.com/content/370/bm…

Español
A. Pérez Landeiro retweetledi

Una nueva edición del curso de #antibióticos del área sanitaria de #vigo
Excelente sesión de la Dra Rebeca Longueira @ProaVigo sobre tratamiento de multiR
@SEIMC_ @GEIRAS_SEIMC @PRANgob #AntimicrobialResistance

Español
A. Pérez Landeiro retweetledi

Nuestro equipo de PROA con las nuevas guías 👏🏼👏🏼
El trabajo que realizan es fundamental para un buen uso de nuestros preciados y valiosos #antibioticos 💊 #cuidemoslosantibioticos @EAAD_EU @PRANgob @SEIMC_ @GEIRAS_SEIMC

Español
A. Pérez Landeiro retweetledi

⚠️ Recordad que la bacteriuria no es una enfermedad! Y por ello, en ausencia de síntomas, de forma general*, no debe ser tratada ❗ #PROA @GEIRAS_SEIMC #cuidemoslosantibioticos
Adi@IDdocAdi
Español
A. Pérez Landeiro retweetledi

⚠️ Empezamos la semana del día del uso prudente de los #antibióticos
#cuidemoslosantibioticos ♥️💊@PRANgob @GEIRAS_SEIMC @ProaVigo


Español
A. Pérez Landeiro retweetledi

Igual de importante que iniciar un antibiótico es saber suspenderlo.
😉No son manías nuestras…son Ensayos Clínicos.
#shorterisbetter #PROA

Español
A. Pérez Landeiro retweetledi

Mejorando el uso de antibióticos en equipo! 👏🏼💪🏻. Sesión de bacteriuria asintomática en el centro de salud de Val Miñor. @jiglmor @GEIRAS_SEIMC @SEIMC_ @PRANgob @FARMACHUVI #antibioticos

Español
A. Pérez Landeiro retweetledi
A. Pérez Landeiro retweetledi
A. Pérez Landeiro retweetledi

✨Very interesting✨
The process of turning a loop of DNA containing the SARS-CoV-2 spike protein into Pfizer–BioNTech vaccine takes 60 days and a jaw-dropping amount of dry ice. Walk through the process and meet the scientists in this step-by-step recipe.
nytimes.com/interactive/20…
English
A. Pérez Landeiro retweetledi

❗️🦠Guía @IDSAInfo para el tratamiento de infecciones resistentes a antimicrobianos: selección del tratamiento empírico, duración, antibiótico de elección y alternativas... academic.oup.com/cid/article/72…


Español
A. Pérez Landeiro retweetledi

Felicidades, un trabajo excelente @HospitalUVRocio
S.E.F.H@sefh_
Os presentamos la 1ª #CápsulasSEFH "Long term impact of an educational antimicrobial stewardship on management of patients with hematological diseases" de @GuisadoAb y col. ¡Enhorabuena por vuestro brillante trabajo! 👏👏 @HospitalUVRocio @FarmaciaHUVR youtube.com/watch?v=NdqSYY…
Español
A. Pérez Landeiro retweetledi

Os recomendamos el comic que ha creado nuestra compañera FAP @mariagg26 junto a @ligero999 con información sobre las resistencias antibióticas dirigido a población general. Lo podéis descargar desde comicresistencias.es No os lo perdáis 👏👏 @ComicResist

Español
A. Pérez Landeiro retweetledi

Ventriculitis asociadas a diapositivos. Importante aumento de bacterias multirresistentes. Nuestra experiencia @ProaVigo @aplandeiro @AdrianaSoPe
sciencedirect.com/science/articl…
Español
A. Pérez Landeiro retweetledi

⚠️Riesgo #errormedicacion con Dexametasona IV en COVID-19
La pauta recomendada en 🇪🇸 para pacientes #COVID19 es 7,2 mg de dexametasona FOSFATO (que es la que contiene las presentaciones comercializadas en España) una vez al día max 10 días
7,2 mg dexa FOSFATO = 6mg dexa BASE

Español
A. Pérez Landeiro retweetledi

Join Prof Jason Roberts and a team of international experts for an update on COVID-19 therapeutics.
Full program: bit.ly/2MtKw9B
Registration: bit.ly/2L0HCc0
@jasonroberts_pk @btccrc

English
A. Pérez Landeiro retweetledi

Muy orgullosos de este trabajo de todo el equipo de @farmachuvi donde se muestra una evaluación muy interesante de la seguridad de los fármacos utilizados para tratar el #COVID19 durante la primera ola de la pandemia.
onlinelibrary.wiley.com/share/author/Q…
@sefh_ @AEMPSGOB @sanidadgob
Español
A. Pérez Landeiro retweetledi

💊⛔👶🏻 Key Potentially Inappropriate Drugs in Pediatrics: The KIDs List
Medicamentos y excipientes que deberían evitarse o usarse con precaución en #pediatria (en todos los pacientes o en algunos subgrupos)
vía @IreneMangues #ASHP20 #sefhmidyear2020 ow.ly/ZNgz50CGBQG

Español


